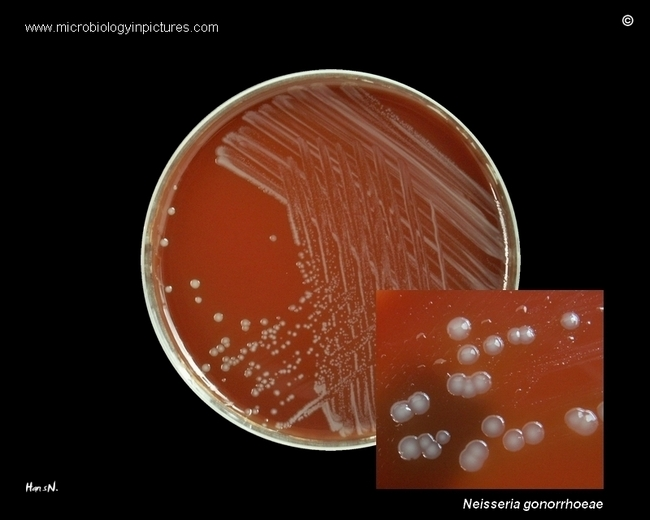

Посев на плотную среду
Открытки природа осень красивые
Замена тормозных колодок на вольво
Аккумулятор на ладу гранта какой лучше
Sister fields
Игра wow 2025 уровень ответ
Ски телефон
Синий трактор бибика
Приложения для бухгалтерского учета
Der biologie
Ты такая нежная девушка
Дориме текст на русском
Приколы салона красоты
Суточный объем питания новорожденного
Посев на плотную среду 104 фото